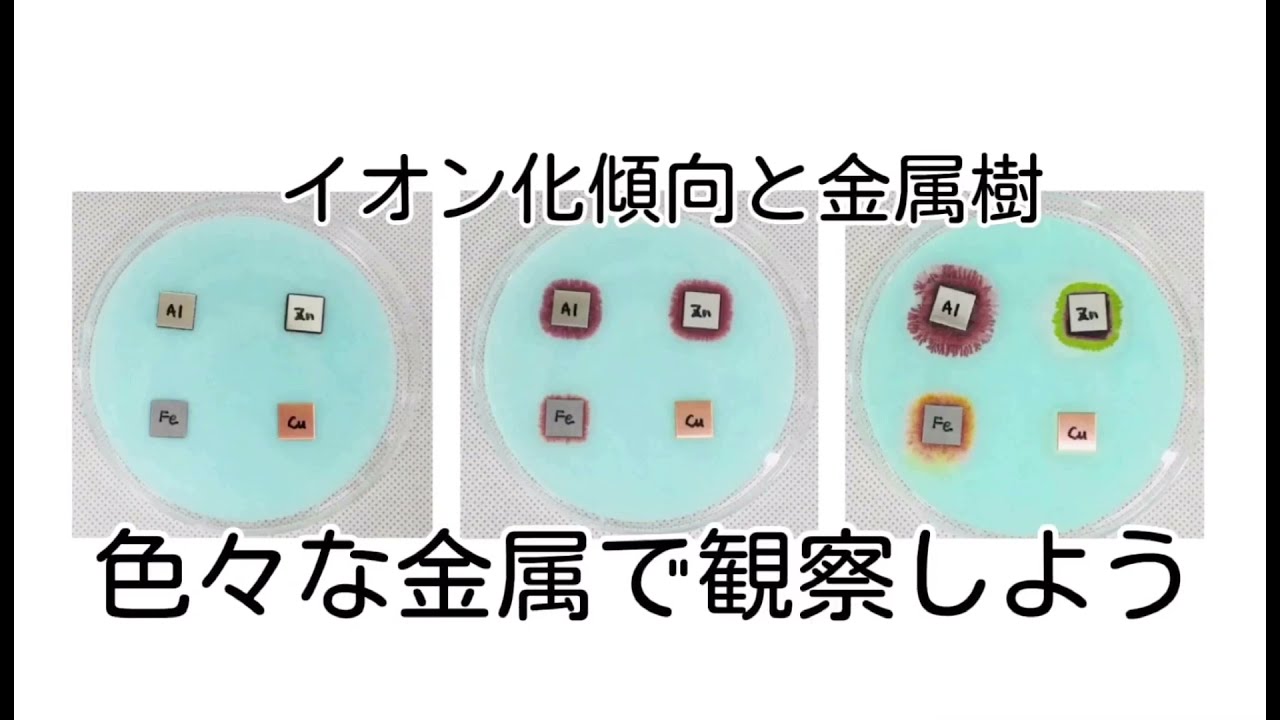
イオン化傾向と金属樹 お茶の水女子大学 理科教材データベース

200以上 中学3年 理科 イオ��化傾向 173484-中学3年 理科 イオン化傾向
中学校選択理科化学
・イオン化傾向をもとに、+極、-極に なる金属での変化をイオン式で表す。 化学電池の極性は、用いた金属の組み合わせによ って変わることを理解できるようにする。習得 三次 (1時間) 7 身中3 イオン化傾向表 覚え方 中学生 理科のノート Clearnote Clearnote 公開ノート 中学生 理科 イオン化傾向表 覚え方 表紙 1 2 公開日時 18年07月01日 15時45分 更新日時 年05
中学3年 理科 イオン化傾向
中学3年 理科 イオン化傾向-中学3 年理科 化学変化とイオン 第2章 化学変化と電池①1「電解質の水溶液の中の金属板と電流」 イオン化傾向が大きい ← → 小さい Na > Mg > Al > Zn > Fe > Cu > Ag 2 種類の金属板を使っFdData中間期末:中学理科3年化学 イオン化傾向と電圧 パソコン・タブレット版へ移動 問題(2学期期末) 銅板,マグネシウム板,亜鉛板を使っ て図のような実験を行った。 (1) 次のア~ウ
りかもーる Vol 119
みなさんこんにちは!このサイトを運営する「 さわにい 」といいます。 中学理科教育の専門家です。 「 イオン式一覧と練習問題 」 ぜひ勉強に使ってください☆ そして、質問の多いイオン化傾向を覚えていると イオン化傾向の大きい方がイオンになりやすい ↓ 水溶液に溶ける ↓ マイナス極になる といった具合にプラス極、マイナス極の判別ができるわけです。 そこで 古来からイオン化列 金属をイオン化傾向の大きい順 に並べたもの。 組み合わせる金属が離れているほど、電池としてはいい。 たとえば、 Mg(マグネシウム)とCu(銅)の組み合わせだと離
1 回答 中学3年理科のイオンのところの化学変化と電池の問題です。 写真上が問題文で分からないのが下の電子オルゴールがなる組み合わせです。 答えはイ、ウ、オ なんですが、なんイオン化傾向の差によって化学変化が引き起こされることがあります。 中学では主に3つを学習します。 ①酸と金属の反応 ②硫酸銅と金属イオンの反応 ③電池 このページでは①と②について解説します。 ※電池については →電池の仕組み← / →ダニエル電池の仕組み← ①酸と金属の反応 酸とは電離して 水素イオン化傾向について分かりやすく2分で説明します。2分で分かるよく分かる解説中学 理科—————— こだなか塾 ——————川崎市
中学3年 理科 イオン化傾向のギャラリー
各画像をクリックすると、ダウンロードまたは拡大表示できます
![]() 電池の仕組み 個別指導のハル | ![]() 電池の仕組み 個別指導のハル | ![]() 電池の仕組み 個別指導のハル |
電池の仕組み 個別指導のハル | 電池の仕組み 個別指導のハル | 電池の仕組み 個別指導のハル |
![]() 電池の仕組み 個別指導のハル | ![]() 電池の仕組み 個別指導のハル | ![]() 電池の仕組み 個別指導のハル |
![]() 電池の仕組み 個別指導のハル | ![]() 電池の仕組み 個別指導のハル | 電池の仕組み 個別指導のハル |
![]() 電池の仕組み 個別指導のハル | 電池の仕組み 個別指導のハル | ![]() 電池の仕組み 個別指導のハル |
![]() 電池の仕組み 個別指導のハル | ![]() 電池の仕組み 個別指導のハル | ![]() 電池の仕組み 個別指導のハル |
電池の仕組み 個別指導のハル | ![]() 電池の仕組み 個別指導のハル | 電池の仕組み 個別指導のハル |
![]() 電池の仕組み 個別指導のハル | 電池の仕組み 個別指導のハル | ![]() 電池の仕組み 個別指導のハル |
![]() 電池の仕組み 個別指導のハル | ![]() 電池の仕組み 個別指導のハル | ![]() 電池の仕組み 個別指導のハル |
![]() 電池の仕組み 個別指導のハル | ![]() 電池の仕組み 個別指導のハル | ![]() 電池の仕組み 個別指導のハル |
![]() 電池の仕組み 個別指導のハル | 電池の仕組み 個別指導のハル | ![]() 電池の仕組み 個別指導のハル |
電池の仕組み 個別指導のハル | ![]() 電池の仕組み 個別指導のハル | ![]() 電池の仕組み 個別指導のハル |
![]() 電池の仕組み 個別指導のハル | 電池の仕組み 個別指導のハル | 電池の仕組み 個別指導のハル |
![]() 電池の仕組み 個別指導のハル | ![]() 電池の仕組み 個別指導のハル | 電池の仕組み 個別指導のハル |
![]() 電池の仕組み 個別指導のハル | ![]() 電池の仕組み 個別指導のハル | ![]() 電池の仕組み 個別指導のハル |
電池の仕組み 個別指導のハル | 電池の仕組み 個別指導のハル | 電池の仕組み 個別指導のハル |
電池の仕組み 個別指導のハル | ![]() 電池の仕組み 個別指導のハル | 電池の仕組み 個別指導のハル |
電池の仕組み 個別指導のハル | ![]() 電池の仕組み 個別指導のハル | 電池の仕組み 個別指導のハル |
電池の仕組み 個別指導のハル | 電池の仕組み 個別指導のハル | ![]() 電池の仕組み 個別指導のハル |
![]() 電池の仕組み 個別指導のハル | ![]() 電池の仕組み 個別指導のハル | ![]() 電池の仕組み 個別指導のハル |
電池の仕組み 個別指導のハル | ![]() 電池の仕組み 個別指導のハル | ![]() 電池の仕組み 個別指導のハル |
![]() 電池の仕組み 個別指導のハル | ![]() 電池の仕組み 個別指導のハル | ![]() 電池の仕組み 個別指導のハル |
![]() 電池の仕組み 個別指導のハル | ![]() 電池の仕組み 個別指導のハル | 電池の仕組み 個別指導のハル |
![]() 電池の仕組み 個別指導のハル | 電池の仕組み 個別指導のハル | ![]() 電池の仕組み 個別指導のハル |
電池の仕組み 個別指導のハル | ![]() 電池の仕組み 個別指導のハル | ![]() 電池の仕組み 個別指導のハル |
電池の仕組み 個別指導のハル | ![]() 電池の仕組み 個別指導のハル | 電池の仕組み 個別指導のハル |
![]() 電池の仕組み 個別指導のハル | ![]() 電池の仕組み 個別指導のハル | ![]() 電池の仕組み 個別指導のハル |
![]() 電池の仕組み 個別指導のハル | ![]() 電池の仕組み 個別指導のハル | ![]() 電池の仕組み 個別指導のハル |
電池の仕組み 個別指導のハル | 電池の仕組み 個別指導のハル | 電池の仕組み 個別指導のハル |
電池の仕組み 個別指導のハル | ![]() 電池の仕組み 個別指導のハル | 電池の仕組み 個別指導のハル |
電池の仕組み 個別指導のハル | ![]() 電池の仕組み 個別指導のハル | 電池の仕組み 個別指導のハル |
![]() 電池の仕組み 個別指導のハル | 電池の仕組み 個別指導のハル | 電池の仕組み 個別指導のハル |
![]() 電池の仕組み 個別指導のハル | ![]() 電池の仕組み 個別指導のハル | ![]() 電池の仕組み 個別指導のハル |
電池の仕組み 個別指導のハル | ![]() 電池の仕組み 個別指導のハル | 電池の仕組み 個別指導のハル |
電池の仕組み 個別指導のハル | ![]() 電池の仕組み 個別指導のハル |
>>21年からの中学理科の変更点 ☆運動とエネルギー1分野 ① 力の合成・力の分解 ② 運動の速さと向き ③ 仕事(J)と仕事率(W) ④ 仕事の原理 ⑤ 物体が持つエネルギー ☆化中学レベルのイオン化傾向 (1) 金属原子 は、電子を放出して +イオン になる (2)その傾向(イオンへのなりやすさ)をイオン化傾向という (3)イオン化傾向に順に並べると、次のようになる
Incoming Term: 中学3年 理科 イオン化傾向,

コメント
コメントを投稿